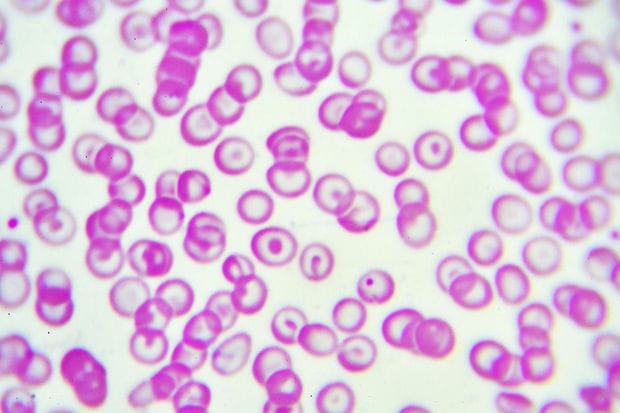

Guérir par des cellules souches modifiées des patients atteints d’une maladie génétique du sang très courante et trop souvent mortelle dans les pays en développement, la thalassémie: l’avancée de pionniers de la thérapie génique donne de l’espoir aux malades.
Les résultats encourageants de ce traitement auprès de 22 patients étaient présentés mercredi dans la revue New England Journal of Medicine.
A lire aussi : Inscription à la vaccination anti-Covid : prenez rendez-vous en ligne
Il est l’oeuvre de l’institut de recherche en génétique parisien Imagine et de l’hôpital Necker (Assistance publique-Hôpitaux de Paris), en collaboration avec une entreprise américaine de biotechnologies, bluebird bio.
La bêta-thalassémie est l’une des maladies génétiques les plus fréquentes: elle touche près de 300.000 personnes dans le monde, surtout originaires d’Asie du Sud-Est. Rare chez les Européens, elle est moins connue en Occident que par exemple la mucoviscidose.
A lire aussi : Société civile – classe politique : la tenue d’une conférence nationale se précise
« C’est une maladie où le gène de la bêta-globine est muté et ne marche plus du tout ou presque plus, empêchant la production d’hémoglobine. (…) Dans la forme la plus grave, on est totalement anémié, et dépendant d’une transfusion sanguine mensuelle à vie », explique à l’AFP le Pr Philippe Leboulch, fondateur de bluebird.
Ces transfusions sont contraignantes, provoquant des excédents de fer dans le corps qu’il faut réduire par traitement.
A lire aussi : Algérie : révélations glaçantes sur le drame du bus de Oued El Harrach
En 2010, la même équipe, celle de la généticienne Marina Cavazzana, avait annoncé avoir conçu la première thérapie génique. Des cellules souches de la moelle osseuse du patient avaient été prélevées, puis « corrigées » par insertion d’un gène-médicament en laboratoire, et ensuite réinjectées sur un patient.
Cette fois, l’article du New England Journal of Medicine montre que la technique est prête pour un emploi à plus grande échelle.
« On fait de l’addition de gène, pour remplacer celui qui fait défaut, grâce à une sorte de cheval de Troie qui va amener l’ADN thérapeutique », indique le Pr Leboulch.
« Pour les patients thalassémiques atteints de la forme grave et sans donneur de moelle compatible, avec des organes encore en bon état, on prélève des cellules souches du sang, on les mélange avec le vecteur, on congèle et on vérifie que le gène est bien rentré dans l’ADN. On décongèle et on place ces patients sous perfusion pour réinjecter ces cellules souches modifiés », ajoute-t-il.
Le « vecteur », appelé LentiGlobin, qui véhicule le gène-médicament, est fabriqué par bluebird bio.
Pour le Pr Cavazzana, les résultats sont spectaculaires. Parmi ces patients traités en France, aux États-Unis, en Thaïlande et en Australie, « aucun ne fait de complication. Il n’y a aucun effet secondaire ». La plupart n’a plus besoin de transfusion, d’autres beaucoup moins.
Un professeur de l’université du Kent, Darren Griffin, a estimé les résultats « incroyablement prometteurs ». « Une avancée significative », selon ce généticien, qui n’a pas participé à l’étude et qui est cité par Science Media Centre.
Le traitement nécessite une chimiothérapie, lors d’un à deux mois d’hospitalisation en milieu confiné.
Une patiente de 20 ans traitée à Paris, d’origine thaïlandaise, a témoigné de sa « deuxième vie ».
« Le traitement était dur, en milieu stérile pendant deux mois. Je ne pouvais pas manger par la bouche. C’était très long de ne pas pouvoir sortir », a-t-elle raconté à l’AFP. « Mais maintenant tout est normal dans ma santé. Je mange de tout, je fais du sport, j’étudie. Enlever les transfusions de ma vie m’a beaucoup soulagée ».